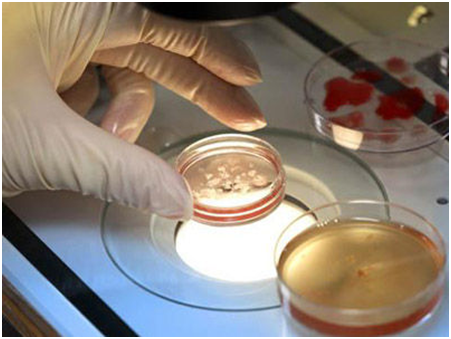

生育二胎是许多大龄夫妻目前最想做的,但因为年龄及身体等因素的影响,只能通过试管婴儿技术的帮助下再生育一个宝宝。做试管婴儿费用要多少,是急需了解清楚的,很多夫妻就比较担心其费用过高,自己无法承担。


试管婴儿
为什么选择做试管婴儿?
试管婴儿是因输卵管不通或切除而不孕的选择,不仅如此,有很多不明原因的不孕不育患者,或者明确了不孕不育的原因,而不能治愈,那么的不孕情况通过试管婴儿可以辅助她们生育。
试管婴儿费用要多少?
试管婴儿取卵
做试管婴儿的费用一般包括三大部分。一部分是术前检查费用,夫妻双方都需要检查,女方要做全面的妇科检查,男方要检查精子;二部分是促排卵药物的费用(患者年龄越大,用药量越大,费用也就越高);另一部分是手术及实验室操作费用。
试管婴儿助孕费用通常在2.5万到3万左右,根据患者身体差异可产生一定的费用差异。因为海外试管婴儿的技术和一对一的服务都要优于国内,成功率也高于国内,去海外做试管的吃住都需要费用,所以价格肯定要比国内高。
试管婴儿配胎
影响试管婴儿费用的因素?
女性年纪越大,试管婴儿成功率越低,可能需要进行多次试管婴儿才能成功妊娠,费用会相应的变高。
如果女方患有妇科炎症,卵巢功能不全、内分泌失调等疾病会降低试管婴儿成功率,增加手术次数,增加费用。
选择哪种的促排卵药物,这就由制定的促排卵方案来决定,国产促排药物与进口药物价格差距较大。
还有一个可能的因素,因为在精液冷冻的进程中,许多精子在超低温环境下质量变差,降低试管婴儿成功,增加试管婴儿费用。





